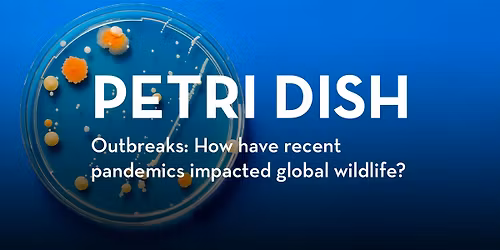
Petri Dish: Outbreaks

Advertisement
6-7pm Guitarra Mike Guitarra Mike (aka Mike Salovich) was born in the tradition of American Primitive Guitar - the original percussive metal fingerpicking of Leo Kottke, Peter Lang, John Fahey. Mike composes original music and now with a million YouTube views has some notoriety in Latin America. At this Guitar Society gig Mike will go back in time and slide on giant metal fingerpicks and a bulky polymer thumb pick to pound out original guitar songs, and share his experience of being steeped in the oral tradition of American Primitive Guitar with Mark Lang - Peter Lang’s long lost swashbuckling genius brother. Guitarra Mike just released a new album of guitar music called “Rosa Mystica” with washboard mystic Mikkel Beckmen, available on all streaming platforms.
7-9pm "The DEANS' List" - solos, duos and trios
Guitarist and composer Dean Granros resides in WI, USA. Over the past 50 years Dean has developed a unique voice on the guitar. Of Dean's playing, New York Times jazz critic, Nate Chinen, wrote: "It was..inarguable in its logic, and to my ears it definitely qualified as something new." As soloist, Mr. Granros explores the intersections of world music and jazz to create a tapestry of musical color and mood.
Dean Harrington earned a Bachelor of Music Degree in Classical Guitar Performance from the University of MN and was a first prize winner in the Schubert Club scholarship competition. For the last two decades he has been exclusively a jazz musician performing with his own band Mill City Hot Club and other local groups. He is proud of his work as a guitar teacher for over 30 years at K & S Conservatory of Music in Woodbury, The Music Lab in Minneapolis, and Mount Olivet School of Music in Edina.
Dean Mikkelson has been performing around the area for over the last twenty years often leading his group Deano and the Dinosaurs. He has also performed with The Mill City Hot Club and recorded with Papa John Kolstad and the Hot Club of East Lake. As a footnote, he was inspired to pursue the guitar after hearing Dean Granros in 1970.
Advertisement
Event Venue & Nearby Stays
385 N Broadway St Suite 104, Saint Paul, MN, United States, Minnesota 55101, 385 Broadway St, St Paul, MN 55101, United States
Concerts, fests, parties, meetups - all the happenings, one place.